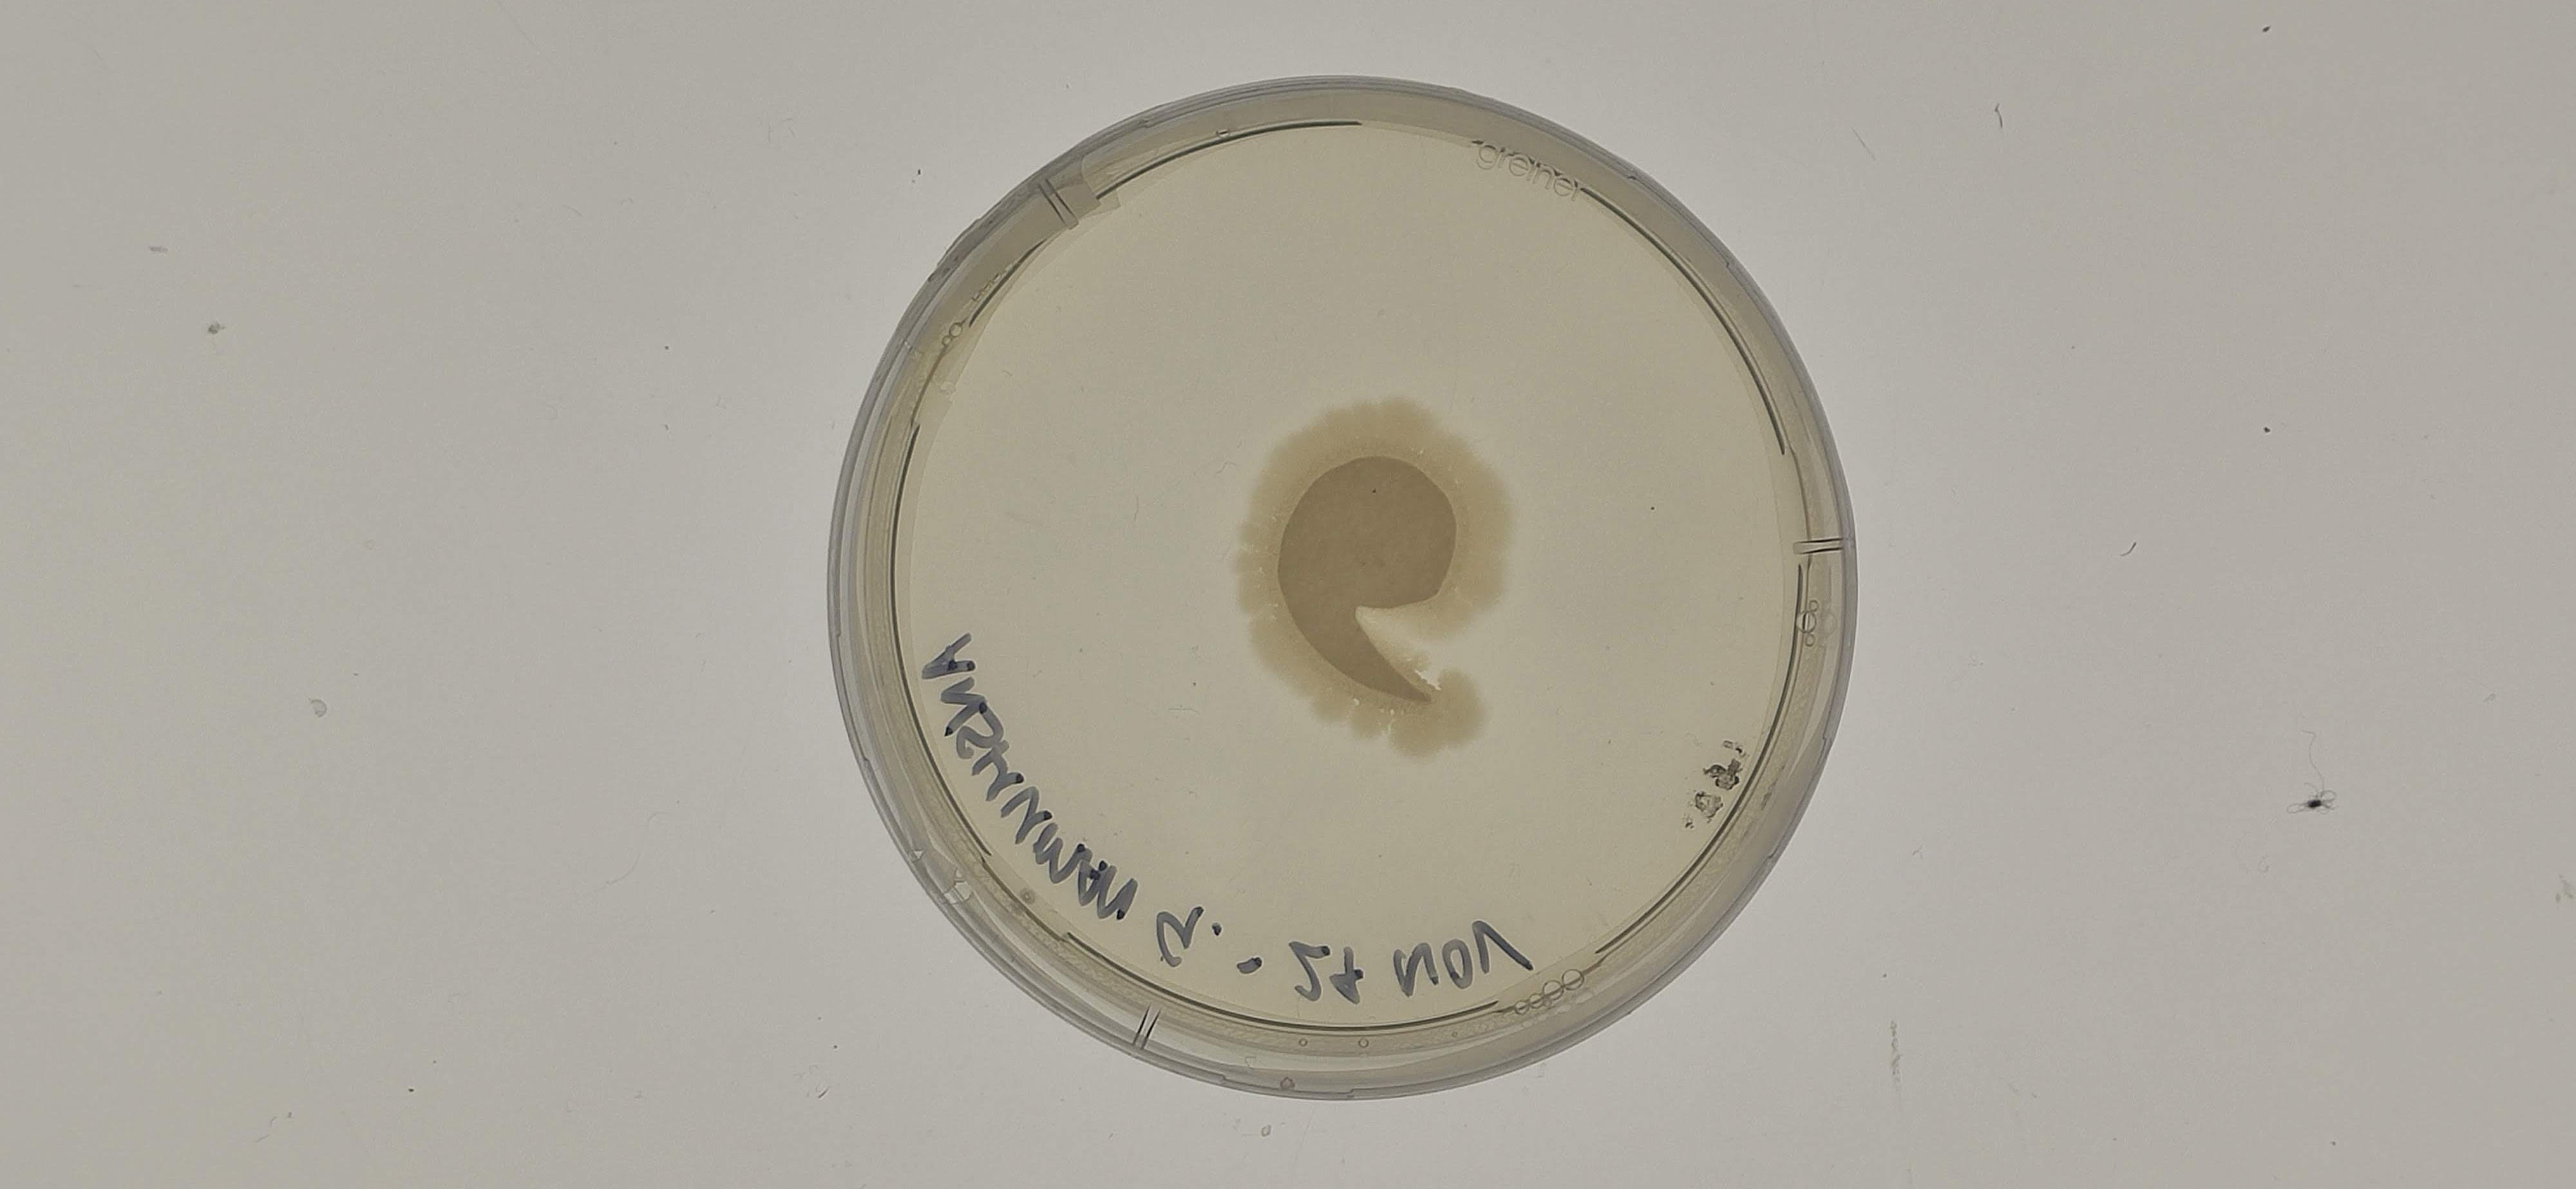

The MA Biodesign at Central Saint Martins specifically understands biodesign as a means to incorporate the inherent life-conducive principles of biological living systems into design processes – to transition into a more holistic, sustainable future. We explore bio-informed design strategies as a driver for sustainable innovation. You will articulate alternative and new innovative design propositions for the emerging bio-circular economy. Through this work, you will redefine the use of energy, water, air, waste and materials.
We provide relevant answers to the complex crisis of material scarcity and ecosystems extinction through inventing machines, instruments and processes which establish novel interfaces for mediation between living organisms and artificial systems.
We look at complex models, natural and artificial intelligence alike across multiple scales and time dimensions to understand interactions between living and non living systems. This understanding of complex interconnectedness of the organic and inorganic and amplification of inter-species relationships is a core component of our design thinking strategy.
Image: Emseed by Mathilde Wittok
We investigate, observe and monitor biological systems. We grow and manipulate living organisms to calibrate design strategies that drive new forms of seeing, thinking, mapping and of making.
We collect samples of living specimens from natural and built environments, then we examine, propagate and analyse them in artificial optimized laboratory conditionals. We instill an ethos of understanding from the micro-scale, in order to provide design solutions at macro and the planetary scales.
Image: CyanoFabbrica by Cinzia Ferrari
We employ scientific and computational methods of data acquisition, data analysis and data visualization. Our combination of science and design curricula encourages hybridization of design disciplines.
The application of multiple data sets requires highly calibrated formal strategies that drive new forms of thinking, mapping, making, and entirely new forms of materiality, products, food, clothing, architecture, urbanism and landscape in the face of the changing scales of manufacturing, processing, and resource movements.
Image: Bioborgs by Anshuman Gupta
MA Biodesign guides you towards a design enquiry. Students develop a personal biodesign agenda which can facilitate our transition to a sustainable way of life. As such, students engage with relevant theoretical, scientific and cultural references. Throughout the course, there is a strong emphasis on ethical issues related to sustainability and biodesign practice.
Landless Food
We are in the year 2050. Agriculture, as we used to know it, barely exists anymore. Our spectrum of natural flavours has been significantly reduced. This loss of agro-biodiversity not only endangers human health, but also the spirituality and cultural importance of culinary traditions. The project, Landless Food, proposes a regeneration of humanity’s food system by introducing a new family of timely flavours, based on microalgae, that bring our culinary memories back on the table. Landless Food presents six food objects as reincarnations of three types of lost flavours.
Learn MoreCo-Obradoiro Galego
The Atlantic Ocean has supplied the Galician and Spanish populations throughout history, resulting in 602 tonnes of seafood exoskeletons being wasted every year. This is a danger to the environment and human health. The decline of basketry, has intensified in the recent years because of the reforestation of non-autochthonous species whose wood cannot be used for basketry, and the disappearance of rural life. Therefore, the objective of our project is to develop a flexible and biodegradable biomaterial from a flexible biopolymer found in the seafood exoskeletons (usually a waste product or unused waste source), chitosan.
Learn MoreThe Unseen Majority
There are 100 million times as many bacteria in the oceans as stars in the known universe - a statistic that is difficult to understand and nearly impossible to visualize. Indeed, the human eye can't see the microscopic life that enables our very existence.This project aims to observe, track and interact with these microbes in order to create a channel of understanding and communication with the invisible majority, specifically looking at the affects and consequences of climate change on this hidden world, and it turn, on the world as we know it.
Learn MorePhyto Printing
Phyto printing is a process in which a light projection is used to control the growth of phytoplankton to create high-resolution prints and living materials that breath and metabolise. My project’s mission is to design a Phyto Printer to make this process accessible to designers, artists, and makers, allowing them to explore the possibilities of this new bio-fabrication process and enable them to develop a huge range of applications. The printer can operate with a variety of materials, such as textiles, ceramics, and paper. It is designed to be easily accessible to its users and adaptable to different settings.
Learn MoreBioborgs
Bioborgs is a digital platform, devised to bridge a communication gap between living organisms and humans, using visualization and actuation channels.It translates the biofeedback data of organisms into tangible outputs, providing real-time information about their physical well-being. The device is built as a biocomputer, which imagines a reality where organisms can interface and act autonomously based on their ecological and environmental threats.The device is built as a biocomputer which provides a platform for organisms to interface and mechanically responds to changes in their ambient environment.
Learn MoreUnder (The) Line
At the intersection of biomimicry, material science, new systems thinking and regenerative design, this project aims at bioremediating air pollution in London Underground stations. This has led to a design which goes beyond the filtering process towards bioremediating air pollution as a resource for the creation of a new type of pigment. Through a self-sufficient filtration system, the urban furniture proposed and the pollution it can store are reusable as pastels. By evolving a design solution within the context of a bio-circular economy, the process only uses local, renewable and bio-based resources.
Learn MoreBi-Oleum
94% of European households throw UCO down the sink generating catastrophic environmental impact.The most disruptive being the effect on aquatic ecosystems and fat-berg sewer blockages. Bi-Oleum is an affordable easy-to-use household kit that attempts to solve this issue. It incorporates a non-pathogenic bacterial strain to bioremediate and remove domestic UCO, producing a clean output. This project challenges current human behaviours by incorporating a living, unharmful bacteria into our daily lives to achieve a sustainable biodesigned solution.
Learn MoreEmotional Iridescence, A Living Colour
Emotional Iridescence: A Living Colour is a biocouture research project demonstrating the development of a bio-based iridescent coating. Made from more than 95% natural and renewable materials, the innovative bio-iridescent film mimics the natural phenomenon of iridescence in nature. This bio-iridescent film is applied to deadstock recycled fabrics and materials, offering new opportunities towards the advocation of greener alternatives for the fashion industry.
Learn More